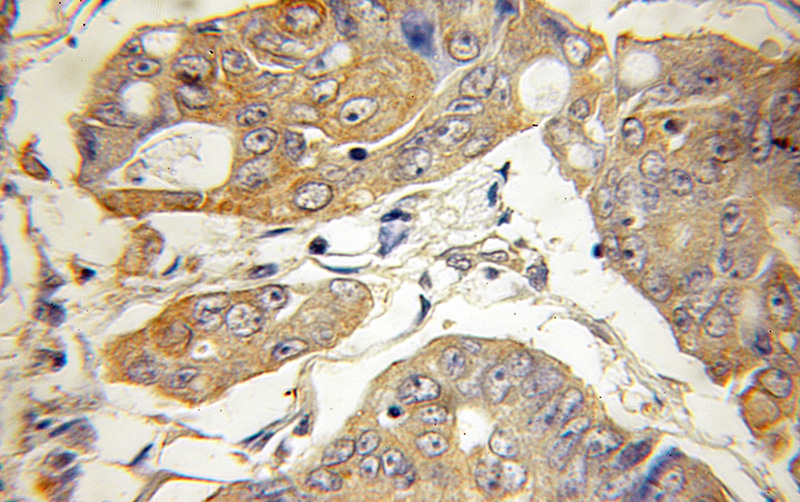
Immunohistochemical of paraffin-embedded human colon cancer using Catalog No:108299(ATG5 antibody) at dilution of 1:50 (under 10x lens)

-
Product Name
ATG5 antibody
- Documents
-
Description
ATG5 Rabbit Polyclonal antibody. Positive WB detected in mouse kidney tissue, human brain tissue, Raji cells. Positive IF detected in mouse cortical neurons. Positive IHC detected in human colon cancer tissue. Observed molecular weight by Western-blot: 50-55kd
-
Tested applications
ELISA, WB, IHC, IF
-
Species reactivity
Human,Mouse,Rat; other species not tested.
-
Alternative names
APG5 antibody; APG5 LIKE antibody; APG5L antibody; Apoptosis specific protein antibody; ASP antibody; ATG5 antibody; Autophagy protein 5 antibody; hAPG5 antibody
-
Isotype
Rabbit IgG
-
Preparation
This antibody was obtained by immunization of ATG5 recombinant protein (Accession Number: NM_004849). Purification method: Antigen affinity purified.
-
Clonality
Polyclonal
-
Formulation
PBS with 0.1% sodium azide and 50% glycerol pH 7.3.
-
Storage instructions
Store at -20℃. DO NOT ALIQUOT
-
Applications
Recommended Dilution:
WB: 1:200-1:2000
IHC: 1:20-1:200
IF: 1:20-1:200
-
Validations

mouse kidney tissue were subjected to SDS PAGE followed by western blot with Catalog No:108299(ATG5 antibody) at dilution of 1:1000
Immunohistochemical of paraffin-embedded human colon cancer using Catalog No:108299(ATG5 antibody) at dilution of 1:50 (under 10x lens)

IF result of anti-ATG5 (Catalog No:108299) with E15 mouse cortical neurons.
-
Background
ATG5, also named as APG5L and ASP, belongs to the ATG5 family. It is required for autophagy. It plays an important role in the apoptotic process, possibly within the modified cytoskeleton. Its expression is a relatively late event in the apoptotic process, occurring downstream of caspase activity. Autophagy is a catabolic process for the autophagosomic-lysosomal degradation of bulk cytoplasmic contents. Formation of the autophagosome involves a ubiquitin-like conjugation system in which Atg12 is covalently bound to Atg5 and targeted to autophagosome vesicles. It mediates autophagosome-independent host protection. This antibody is raised against 28-275 amino acids of human ATG5. It can recognize the ATG5-ATG12 complex (55 kDa) and free ATG5 (32 kDa).
-
References
- Xu ZX, Liang J, Haridas V. A plant triterpenoid, avicin D, induces autophagy by activation of AMP-activated protein kinase. Cell death and differentiation. 14(11):1948-57. 2007.
- Li J, Liu Y, Wang Z. Subversion of cellular autophagy machinery by hepatitis B virus for viral envelopment. Journal of virology. 85(13):6319-33. 2011.
- Yuan X, Du J, Hua S. Suppression of autophagy augments the radiosensitizing effects of STAT3 inhibition on human glioma cells. Experimental cell research. 330(2):267-76. 2015.
- Zhu X, Ruan Z, Yang X. Connexin 31.1 degradation requires the Clathrin-mediated autophagy in NSCLC cell H1299. Journal of cellular and molecular medicine. 19(1):257-64. 2015.
- Liu E, Van Grol J, Subauste CS. Atg5 but not Atg7 in dendritic cells enhances IL-2 and IFN-γ production by Toxoplasma gondii-reactive CD4+ T cells. Microbes and infection / Institut Pasteur. 17(4):275-84. 2015.
- Jin R, Zhu W, Cao S. Japanese encephalitis virus activates autophagy as a viral immune evasion strategy. PloS one. 8(1):e52909. 2013.
- Lu Y, Zhang Z, Sun D, Sweeney ST, Gao FB. Syntaxin 13, a genetic modifier of mutant CHMP2B in frontotemporal dementia, is required for autophagosome maturation. Molecular cell. 52(2):264-71. 2013.
- Wei PF, Jin PP, Barui AK. Differential ERK activation during autophagy induced by europium hydroxide nanorods and trehalose: Maximum clearance of huntingtin aggregates through combined treatment. Biomaterials. 73:160-74. 2015.
Related Products / Services
Please note: All products are "FOR RESEARCH USE ONLY AND ARE NOT INTENDED FOR DIAGNOSTIC OR THERAPEUTIC USE"
